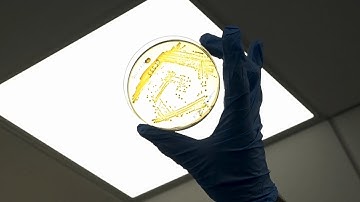
Bacteria‐Based Materials for Stem Cell Engineering

⬇ DOWNLOAD NOW
Kalau muncul iklan pop-up, tutup lalu klik tombol kembali
Download lagu Biomaterials & Stem Cell Engineering Lab secara gratis hanya untuk keperluan promosi. Dukung artis favorit kamu dengan membeli musik original di iTunes atau platform resmi lainnya.
 Advancements in Biomaterials and Tissue Engineering (5 Minutes)
Advancements in Biomaterials and Tissue Engineering (5 Minutes)
 Tissue Engineering and Regenerative Medicine
Tissue Engineering and Regenerative Medicine
 How scaffold and biomaterials help regeneration?
How scaffold and biomaterials help regeneration?
 Biomaterials for Personalized Medicine Medicine Combining Engineering with Stem Cell
Biomaterials for Personalized Medicine Medicine Combining Engineering with Stem Cell
Bacteria‐Based Materials for Stem Cell Engineering
Bacteria‐Based Materials for Stem Cell Engineering
 Engineering stem cell therapies for diseases | Michael Garton Lab
Engineering stem cell therapies for diseases | Michael Garton Lab
 Biomaterials for Personalized Medicine: Combining Engineering with Stem Cells
Biomaterials for Personalized Medicine: Combining Engineering with Stem Cells
 Biomedical technologies: Coupling stem cell and biomaterial approaches to regenerate damaged tissue
Biomedical technologies: Coupling stem cell and biomaterial approaches to regenerate damaged tissue